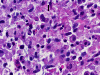
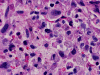
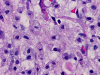

FLAIR
FLAIR
T1+Contrast
T1+Contrast
| A 52 year-old Man with
History of Endocardititis, Storke, and
delirium. July, 2007, Case 707-1. Home Page |
Clinical information:
This patient was a 52 year-old right handed man with past medical history of infective endocarditis status post aortic valve replacement and he was on Coumadin. There was also history of depression, hepatitis C, and old right posterior cerebral artery stroke. He was transferred to our institution about 4 months ago from an outside facility after four days of dilirium.
Neurologic and mental examination showed intact immediate memory but inability to recall 3 objects in 5 minutes. He was not oriented to time or space or situation but oriented to person. His remote memory was intact. There was left superior quadrantonopsia but no focal motor or sensory deficits. FLAIR images on MRI showed a lesion in the left mesial temporal lobe (Panel 1). This lesion had increased T2 signal but without enhancement on T1 images. This lesion also had mass-effect and edema within that region. On FLAIR images, there were some small foci of abnormal signal in the white matter of the right parietal lobe (Panel 2) but these foci did not enhance (Panel 3). There is a vague, poorly demarcated, triangular shaped periventricular signal abnormality in the left parietal lobe (Panel 2) but this area did not enhance (Panel 3). On another image (obtained higher to Panel 2 and 3), however, there is a small cluster of enhancing spotty signal in the white matter of the left parietal lobe (Panel 4) and the largest focus is about 0.4 cm in diameter. There were areas with features of encephalomalacia in his right mesial temporal lobe that would be explained by his history of prior infarct.
 |
 |
 |
 |
||
|
1. FLAIR |
2. FLAIR |
3. T1+Contrast |
4. T1+Contrast |
The initial clinical diagnosis was herpes encephalitis and he was treated with acyclovir. Lumbar puncture performed a few days later showed RBCs of 10, WBC of 8, 100% lymphocytes, protein 68 and glucose 71. An echocardiogram performed by then showed an ejection fraction of 65% with normal aortic mechanical valve in place. PCR study for herpes simplex virus (HSV) was negative.
During the course of his first hospital stay his suicidal thoughts increased but he continued to remain amnestic for recent events and tried to write down the details of his room, his belongings and so forth. He completed 10 days of acyclovir. He was housed in the psychiatric ward because of his suicidal ideation. He was discharged a month later on Coumadin and a therapeutic INR and was followed in the neurologic clinic.
He continued to have amnesia. About 2 months after the initial MRI, another MRI performed at an outside facility reported an enhancing mass in his left parietal lobe. This mass apparently grew from a 0.4 cm lesion in the left mesial temporal lobe in the previous study. The mass was 2.5 cm in greatest dimension and was distinctly separated from the left lesions in his mesial temporal lobe albeit the edema from both lesions were somewhat coalescing (Panel 5 and 6). The non-enhancing lesions in the right parietal white matter remained unchanged (Compare Panel 2 and 5).
 |
 |
||||
| 5. | 6. |
He was admitted again. In this admission, he developed left intraparenchymal hemorrhage associated with the enhancing mass, edema, and 0.4 cm left to right midline shift. A craniectomy was performed to evacuate the blood and biopsy the enhancing mass. The followings are representative images from the biopsy material.
 |
 |
 |
 |
 |
 |
 |
|
A. Squash |
B. Squash |
C. Squash |
D. Squash |
E. Squash |
F. Frozen |
G. Frozen |
 |
 |
 |
|
|
|
 |
|
H. Frozen |
I. Frozen |
J. Frozen |
K. |
L. | M. | N. |
Panel A to E are intra-operative cytologic preparation, Panel E to J are frozen section, Panel K to N are permanent sections.
What is your diagnosis? Discussion